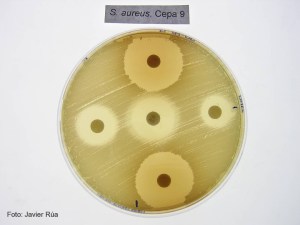
15970

Un equipo internacional de investigadores ha diseñado un nuevo antibiótico que ha demostrado ser eficaz contra el estafilococo dorado, la bacteria responsable de buena parte de las infecciones que se contraen en los hospitales y un microorganismo resistente a casi todos los antibióticos.
http://www.efefuturo.com/noticia/antibiotico-eficaz-infecciones-hospitalarias/